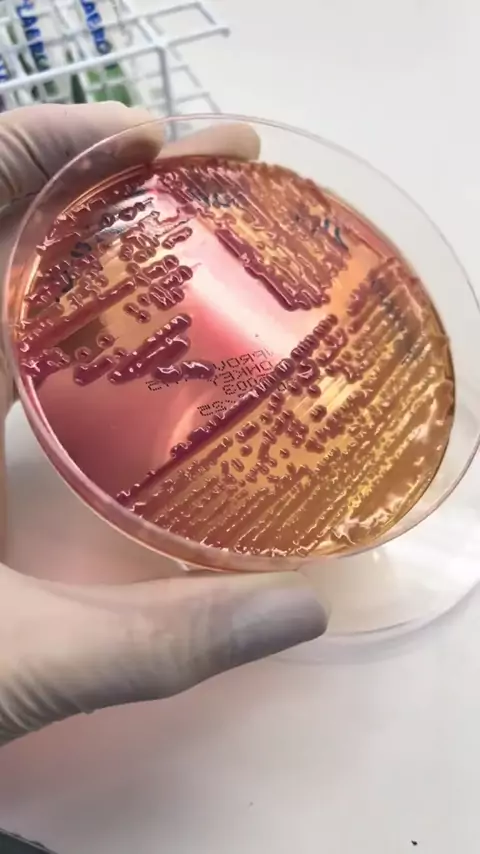
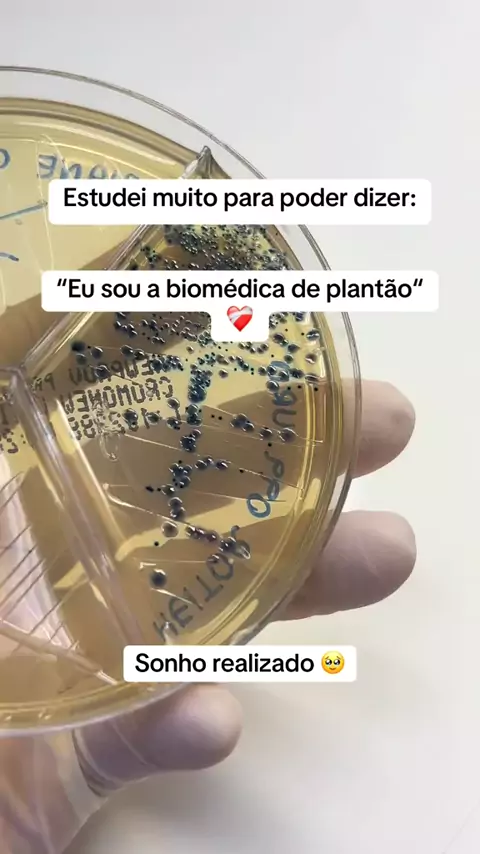

Googlestars & BioMedEstudos

322
Posts

All playlists · Total 10

2
Sim eu estou trabalhando! #Deus #MarketingDigital #DicasDeMarketing #Empreendedorismo #NegóciosOnline

2
É isso aí fazemos de tudo! 😮💨 #Deus #Googlestars #vida #markenting #Biomedestudos
2
Bactérias em foco! #Deus #Biomedestudos #ciência #Saúde #vida

2
Biomedicina ❤️! #DEUS #ciência #biomedstudos #Saúde

6
Marketing Digital #presençadigital #CresçaComAGente #EstratégiasDeVenda

2
Marketing digital! #empreendedorismo #googlestars #batevoltakwai #dinheir9🤑🔥🚀

3
Pode mudar sua vida! #marketing #empreendedor #dinheiro #online

2
Marketing é importante #empreendedor #empreendedorismo #online #dinheiro

2
5 Vantagens de Trabalhar com Marketing Digital Quer saber por que essa é uma das áreas que mais crescem no mercado? Descubra como o marketing digital pode te dar mais liberdade, flexibilidade e ótimos ganhos! Assista até o final e veja como transformar seu tempo online em oportunidades de negócio! #MarketingDigital #TrabalhoOnline #GanheDinheiro #Empreendedorismo #GoogleStars

2
Conquistei o bronze no Kwai! Uma jornada de muita dedicação e conteúdo para vocês! Agradeço por todo o apoio e por estarem comigo nesse caminho. Vamos continuar crescendo juntos! #Kwai #Conquista #Bronze #Gratidão #VamosCrescer